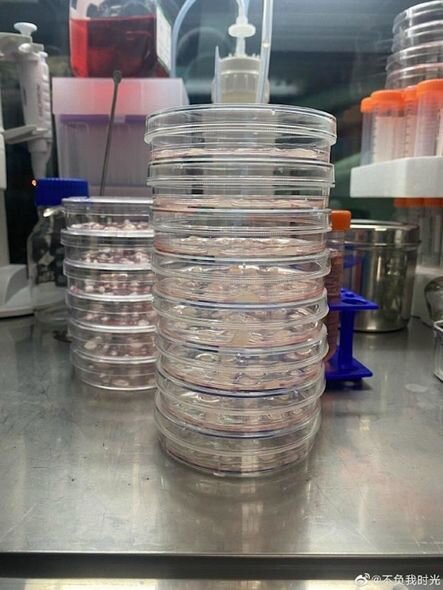
Oğlunu sağaltmaq üçün evində laboratoriya düzəltdi - FOTO

Oğlunu sağaltmaq üçün evində laboratoriya düzəltdi - FOTO
 Çində kiçik bir onlayn mağazanın sahibi ölümcül xəstə oğlunun müalicəsi üçün kimyanı öyrənməyə və genetik araşdırmalara başlayıb.
Çində kiçik bir onlayn mağazanın sahibi ölümcül xəstə oğlunun müalicəsi üçün kimyanı öyrənməyə və genetik araşdırmalara başlayıb.
Yunnan əyalətinin Kunmin şəhərindən olan Syuy Veyin bir yaşlı oğluna Menkes xəstəliyi diaqnozu qoyulub. Belə hallarda ömür müddəti üç ildən çox olmur. Eksperimental klinikada müalicə xeyir eləmədiyi, həmçinin Çində müalicə üçün əhəmiyyətli olan mis histidin əldə edə bilmədiyi (pandemiyanın yaratdığı məhdudiyyətlərə görə onun xaricdən gətirilməsi də mümkün olmur) üçün orta məktəb təhsili olan Vey dərmanı özü hazırlamaq qərarına gəlir.
O, müstəqil şəkildə kimyanı öyrənməyə başlayır. Məlumatları isə ABŞ-ın elmi jurnallarından götürür. Bundan başqa bir neçə universitetdə ictimai kurslara yazılır və farmasevtliyi öyrənməyə başlayır.
Tezliklə o, mənzilində 3100 dollara kimyəvi laboratoriya qurur və dərman hazırlamağa başlayır.
O, mis histidi əldə etdikdən sonra komponenti dovşanların, ardınca isə öz üzərində sınayıb, təhlükəsizliyinə əmin olduqdan sonra isə oğluna vurub. Daha sonra o, oğlunu xəstəxanaya analizlər üçün aparıb.
Bir müddət sonra Syuy Vey Menkes xəstəliyində yardımı görünən daha bir preparat – elesklomol hazırlayır və əvvəl dovşanlarda, sonra isə özündə sınaqdan keçirdir.
"Dərman oğlumu sağaltmasa da, halının pisləşməsinin qarşısını aldı", - deyə ata bildirib.
Qeyd edək ki, Veyin oğlu sərbəst hərəkət edə, danışa bilmir, ancaq duru yemək yeyir. Bununla belə onu güldürəndə gülür. Syuy Vey genetika sahəsində tədqiqatların oğlunu sağaldacağına ümid edir. Hazırda kişi genetik mühəndisliyi öyrənmək üçün universitetə hazırlaşır.
"Hesab edirəm ki, bütün çətinliklərin öhdəsindən gəlmək olar və ümid edirəm ki, oğlum düzələcək. Mən sadəcə əlimdən gələni etməliyəm", - deyə kişi bildirib.
Yerli Səhiyyə qurumundan bildirilib ki, Syuy Vey dərmanı ancaq öz oğlu üçün istehsal etdiyi müddətdə və onu üçüncü şəxsə satmadığı halda hökumət onu məsuliyyətə cəlb etməyəcək./Oxu.az





Sonxeber.az
 Telegramda izləyin
Telegramda izləyin
Dünyada Baxılıb: 1244 Tarix: 16 oktyabr 2021
Şikayətiniz varsa Whatsapp: 077 7125666
Facebookda Paylaş
Dünyanın ən bahalı şəhəri seçildi
Qlobal daşınmaz əmlak bazarında qiymətlər rekord həddə çatmağa davam edir. "Qafqazinfo" xəbər verir ki, yeni hesabatlara görə, dünyanın ən bahalı şəhəri kimi Monako yenidən ön sıralarda yer alıb. Burada daşınmaz əmlak o qədər bahalaşıb ki, böyük məbləğlərə belə yalnız çox kiçik sahələr alma
30 aprelAlimdən iddia: İnsanlar 3 ildən sonra keçmişə səyahət edə biləcək
Bəzi futuristlərə görə, texnologiyanın inkişafı insan həyatının orta müddətini əhəmiyyətli dərəcədə uzada bilər. Qaynarinfo xəbər verir ki, bu barədə "Popular Mechanics" yazır. Qeyd olunur ki, futurologiya sahəsində "uzunömürlülükdən qaçış sürəti" adlı ideya müzakirə olunur. "Bu
1 mayDünyanın ən böyük "zombi qurdlar" məskəni: Bu, hansı mağaradır?
Okeanın beş əsas zonasından dördüncüsü olan abissopelagik (abissal) zona 400 metr dərinlikdən başlayaraq təxminən 600 metrə qədər uzanır. Müqayisə üçün qeyd edək ki, Yaponiyanın ən hündür dağı olan 3776 metrlik Fuci bu dərinliyə çatmır. Hətta 5895 metr hündürlüyündəki Kilimancaro belə bu zonaya yerləşdirilsəydi
29 aprelDonald Trampın bu rəftarı geniş müzakirələrə səbəb oldu - VİDEO
ABŞ Prezidenti Donald Trampın rəsmi mərasim zamanı Böyük Britaniya Kraliçası Kamillanın önünə keçməsi beynəlxalq mediada geniş müzakirələrə səbəb olub. xəbər verir ki, yayılan görüntülər protokol qaydaları ilə bağlı mübahisələri yenidən gündəmə gətirib. Bəzi ekspertlər bu addımı "qeyri-adi davranış"
29 aprelDonald Tramp: "ABŞ Kubanı dərhal öz nəzarətinə alacaq"
Amerika Birləşmiş Ştatlarının Prezidenti Donald Tramp, ABŞ-nin Kubanı dərhal öz nəzarəti altına almağı planlaşdırdığını bildirib. xəbər verir ki, o bu barədə Florida ştatının Uest-Palm-Biç şəhərində yerli "Forum" klubunun üzvləri qarşısında çıxışı zamanı danışıb. Ağ Ev lideri Kubanın adın
2 mayİsveçrədə 2000 illik Roma çörəyi tapıldı
İsveçrədə Sürix yaxınlığında yaşayış kompleksinin tikintisi zamanı aparılan qazıntılar zamanı təxminən 200 illik kömürləşmiş Roma dövrünə aid çörək parçası aşkarlanıb. Qaynarinfo-un "Popular Science"a nəşrinə istinadən məlumatına görə, tapılan artefaktın eni təxminən 4 düym, qalınlığı isə
27 aprel Çində kiçik bir onlayn mağazanın sahibi ölümcül xəstə oğlunun müalicəsi üçün kimyanı öyrənməyə və genetik araşdırmalara başlayıb.
Çində kiçik bir onlayn mağazanın sahibi ölümcül xəstə oğlunun müalicəsi üçün kimyanı öyrənməyə və genetik araşdırmalara başlayıb.

Telegramda izləyin
Telegramda izləyin












 Hava nə vaxt düzələcək? - Gülşad Məmmədova AÇIQLADI
Hava nə vaxt düzələcək? - Gülşad Məmmədova AÇIQLADI Heydər Əliyevlə xanımının yeni - Fotoları
Heydər Əliyevlə xanımının yeni - Fotoları Evində bu səhvi edənlər 600 manat cərimə ÖDƏYƏCƏK
Evində bu səhvi edənlər 600 manat cərimə ÖDƏYƏCƏK Bakı metrosunda bu cür oturanlar HƏBS OLUNACAQ - VİDEO
Bakı metrosunda bu cür oturanlar HƏBS OLUNACAQ - VİDEO Ailəsini amansızlıqla qətlə yetirən Əhməd müalicə aldığı müəssisədən qaçıb?
Ailəsini amansızlıqla qətlə yetirən Əhməd müalicə aldığı müəssisədən qaçıb? Elvin Cəfərquliyev ilk oyununa çıxdı, qol vurdu - Yenilənib
Elvin Cəfərquliyev ilk oyununa çıxdı, qol vurdu - Yenilənib Dırnaq qaynağının hansı zərərləri var? - AÇIQLAMA
Dırnaq qaynağının hansı zərərləri var? - AÇIQLAMA Keçmiş məhkəmə sədrindən Şok DƏLƏDUZLUQ: Vəzifəsindən istifadə edib sənədləri saxtalaşdıraraq restoranını icarəyə verib
Keçmiş məhkəmə sədrindən Şok DƏLƏDUZLUQ: Vəzifəsindən istifadə edib sənədləri saxtalaşdıraraq restoranını icarəyə verib Milli Onkologiya Mərkəzindəki partlayışda xəsarət alan həkim ölüb? - RƏSMİ AÇIQLAMA
Milli Onkologiya Mərkəzindəki partlayışda xəsarət alan həkim ölüb? - RƏSMİ AÇIQLAMA Aygün Kazımovanın səhhəti pisləşdi - Konserti təxirə salındı
Aygün Kazımovanın səhhəti pisləşdi - Konserti təxirə salındı Prezidentlə ailəsi İslam Səfərli küçəsinin açılışında
Prezidentlə ailəsi İslam Səfərli küçəsinin açılışında Metro və avtobuslarda gedişhaqqı ilə bağlı YENİLİK
Metro və avtobuslarda gedişhaqqı ilə bağlı YENİLİK Maaşlarla bağlı dəyişiklik təsdiqləndi - BUNDAN SONRA BELƏ OLACAQ
Maaşlarla bağlı dəyişiklik təsdiqləndi - BUNDAN SONRA BELƏ OLACAQ Təranə Əhmədova Səhiyyə Nazirliyindən getdi
Təranə Əhmədova Səhiyyə Nazirliyindən getdi Ölkədə pensiya yaşı 60-a SALINIR?
Ölkədə pensiya yaşı 60-a SALINIR?